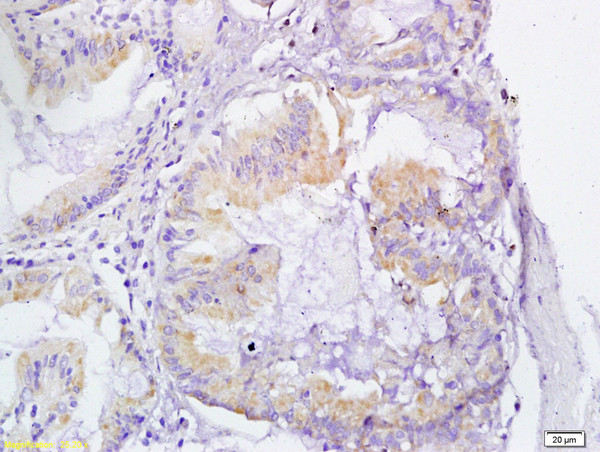
VEGFR3 Antibody in Immunohistochemistry (Paraffin) (IHC (P))

Search
Bioss
VEGFR3 Polyclonal Antibody
{{$productOrderCtrl.translations['antibody.pdp.commerceCard.promotion.promotions']}}
{{$productOrderCtrl.translations['antibody.pdp.commerceCard.promotion.viewpromo']}}
{{$productOrderCtrl.translations['antibody.pdp.commerceCard.promotion.promocode']}}: {{promo.promoCode}} {{promo.promoTitle}} {{promo.promoDescription}}. {{$productOrderCtrl.translations['antibody.pdp.commerceCard.promotion.learnmore']}}
产品信息
BS-2202R
种属反应
宿主/亚型
分类
类型
抗原
偶联物
形式
浓度
规格
纯化类型
保存液
内含物
保存条件
运输条件
靶标信息
Vascular endothelial growth factor is a key regulator of blood vessel development in embryos and angiogenesis in adult tissues. Unlike VEGF, the related VEGFC stimulates the growth of lymphatic vessels through its specificl ymphatic endothelial receptor VEGFR-3. In 1998, Dumont showed that targeted inactivation of the VEGFR-3 gene in mice resulted in defective blood vessel development in early embryos. Vasculogenesis and angiogenesis occurred, but large vessels became abnormally organized with defective lumens, leading to fluid accumulation in the pericardial cavity and cardiovascular failure at embryonic day 9.5. Thus, VEGFR3 has an essential role in the development of theembryonic cardiovascular system before the emergence of the lymphatic vessels.
仅用于科研。不用于诊断过程。未经明确授权不得转售。
篇参考文献 (0)
生物信息学
蛋白别名: alternatively spliced; chylous ascites; Feline McDonough Sarcoma (FMS)-like tyrosine kinase 4; FLT-4; fms related tyrosine kinase 4; FMS-like tyrosine kinase 4; primary congenital lymphedema; receptor protein tyrosine kinase; soluble VEGFR 3; sVEGFR 3; Tyrosine-protein kinase receptor FLT4; unnamed protein product; Vascular endothelial growth factor receptor 3; vascular endothelial growth factor receptor-3; VEGF R3; VEGF receptor-3; VEGFR-3
基因别名: AI323512; CHTD7; Chy; FLT-4; FLT4; FLT41; LMPH1A; LMPHM1; PCL; VEGFR-3; VEGFR3
UniProt ID: (Human) A8K6L4, (Rat) Q91ZT1, (Mouse) P35917
Entrez Gene ID: (Human) 2324, (Bovine) 338031, (Rat) 114110, (Mouse) 14257